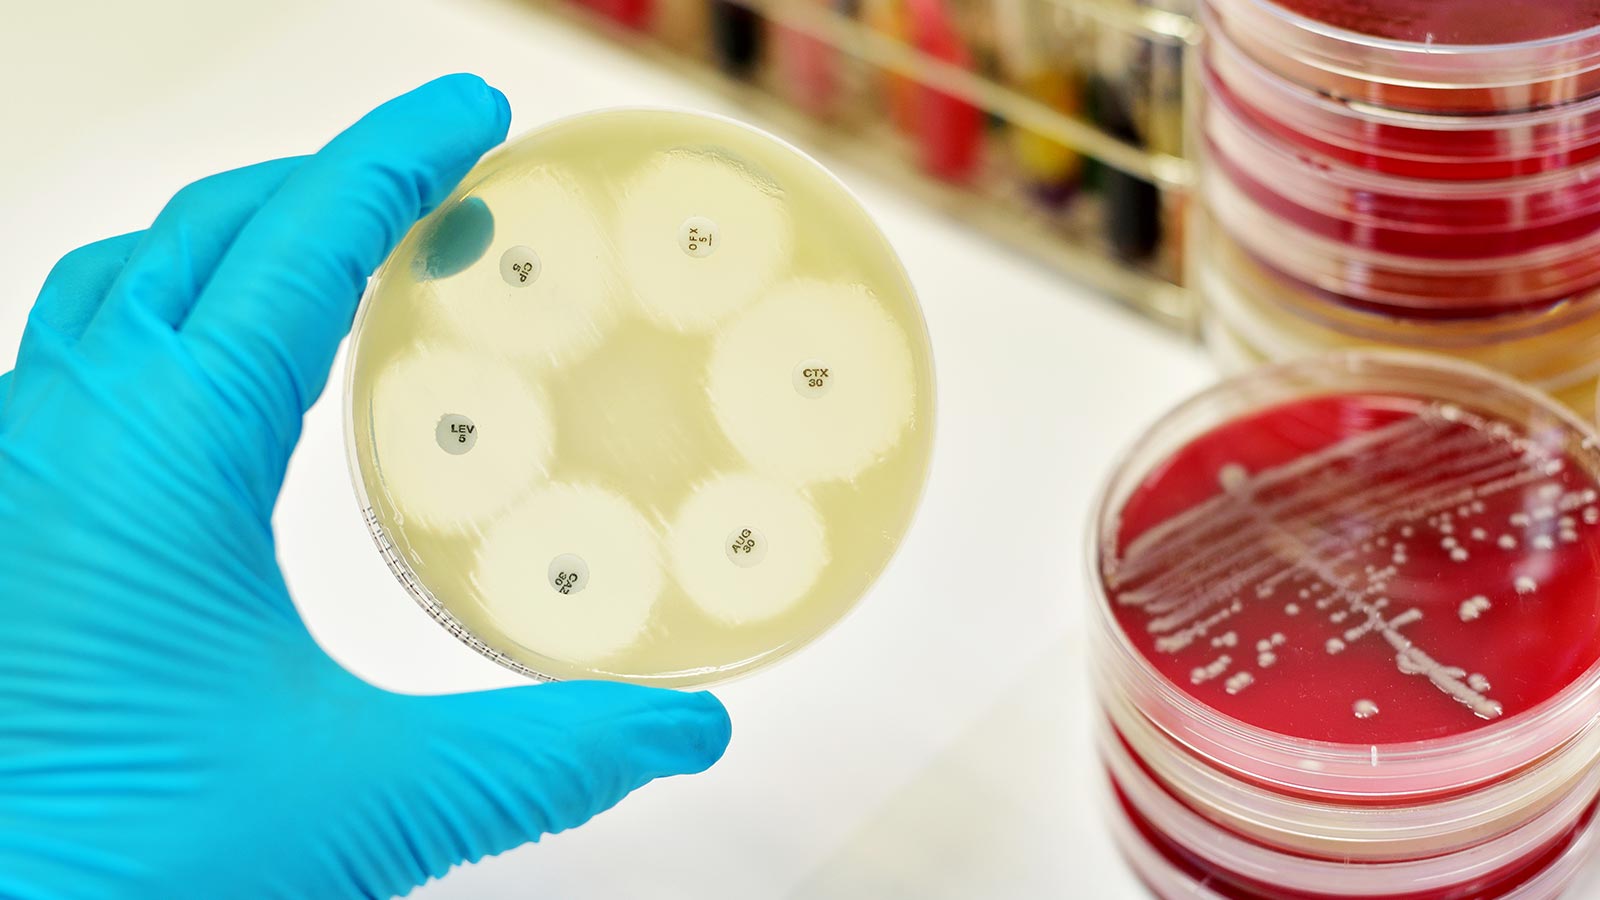
Problema de salud pública: uso de antibióticos en animales

Resistencia a los antibióticos: 10 cosas que deberías saber
Se calcula que unos 25.000 pacientes fallecen cada año en la Unión Europea debido a infecciones causadas por bacterias resistentes a los antibióticos. Con frecuencia a las personas se nos dice que no abusemos de los antibióticos, pero ¿sabías que los animales tampoco deberían hacerlo?
Además de los antibióticos que consumimos los humanos para tratar nuestras enfermedades, los antibióticos llegan a nosotros por otras vías, por ejemplo, a través de los alimentos que consumimos. El abuso de los antibióticos en animales cuya carne o derivados consumimos es un grave problema de salud pública. En la Unión Europea, el consumo de antibióticos es mayor en los animales productores de alimentos que en los humanos, y España tiene el dudoso honor de ser el líder en uso de antibióticos en animales.

Con el objetivo de mejorar las condiciones higiénicas en las granjas, prohibir el uso preventivo de antibióticos en animales de granja de forma rutinaria y reducir las condiciones estresantes a los que están sometidos, nos sumamos a la campaña europea puesta en marcha por el BEUC, para exigir a los Ministerios de Sanidad y Agricultura de toda la Unión Europea un uso más responsable de los antibióticos en los animales destinados a la producción de alimentos.
En la Unión Europea, de media, el consumo de antibióticos es más elevado en animales destinados a la producción de alimentos que en humanos. Por ejemplo, en España, Chipre, Italia y Alemania, en 2014, el uso de antibióticos en animales de granja duplicó el uso en humanos.
Cuando uno tiene una infección causada por un virus (como un resfriado, una gripe o la mayoría de los procesos infecciosos de garganta y bronquitis) los antibióticos no sirven de nada. Los antibióticos solo combaten las infecciones causadas por bacterias, como una neumonía, la tuberculosis o las infecciones del tracto urinario. Y con los animales sucede lo mismo. Por eso solo habría que darles antibióticos cuando los prescribe el veterinario.
Cuando se habla de resistencia a los antibióticos, muchos asumen que son las personas o los animales los que desarrollan esa resistencia. Sin embargo, las que se vuelven resistentes a los antibióticos son las bacterias que causan las enfermedades. Estas bacterias resistentes pueden infectar tanto personas como animales, y las infecciones a las que dan lugar son más difíciles de tratar que las causadas por bacterias no resistentes.
Ya sea de forma natural o porque han mutado, algunas bacterias tienen genes que les permiten resistir a los efectos de los antibióticos. Se las conoce como “superbacterias”. Mientras los antibióticos matan a la mayoría de las bacterias, estas superbacterias sobreviven y se multiplican, especialmente cuando los antibióticos se usan de forma incorrecta. Estas superbacterias pueden transmitir sus genes de resistencia a otras bacterias.
En aquellos países (especialmente del norte de Europa) en los que los gobiernos han tomado medidas para reducir el uso de antibióticos en las granjas se observa una disminución de los niveles de resistencia a los antibióticos, que de nuevo vuelven a ser efectivos. Sin embargo, algunos países de la Unión Europea se están quedando atrás en la lucha contra la resistencia a los antibióticos generada en la producción animal. Por ejemplo, en el año 2014, la venta de antibióticos para producción animal fue 36 veces superior en España que en Suecia.
